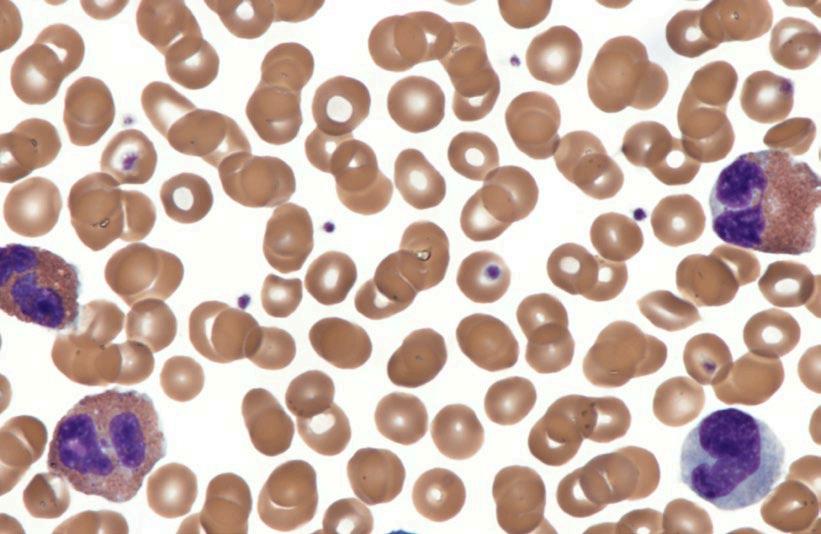

GRUPO DE COMUNICACIÓN AGRINEWS LLC
Luis Carrasco +34 605 09 05 13 lc@agrinews.es
Adoración Guerrero Guzmán +(34) 664 66 06 05 int@grupoagrinews.com
Nicole Carletti Ramírez +57 312 391 9330 avinewslatam@grupoagrinews.com
Mercé Soler
José Luis Valls
Osmayra Cabrera
María de los Angeles Gutiérrez
Nicole Carletti Ramírez Héctor David Corredor Martínez
Edgar Oviedo Eduardo Cervantes


aviNews Legal Deposit B11597-2013
Winfridus Bakker winfridus.bakker@gmail.com

Udaykumar (Uday Patil) Mudbakhe








Guillermo Tellez - Isaias

Edgar O. Oviedo - Rondon

Edgar O. Oviedo - Rondon



Michael Czarick 1 & Brian Fairchild 2























Udaykumar (Uday Patil) Mudbakhe








1 2 3 4 5



































It all starts with genetics.
The tiniest edge can make a huge difference: in poultry genetics, but also in animal health, food security, production efficiency and more. The Cobb Research Initiative (CRI) is our commitment to advancement, and our grant recipients are pushing boundaries across the poultry supply chain to tackle challenges and help ensure that we can meet the demand for healthy, sustainable and affordable protein worldwide.







EVERY STAGE. EVERY CHALLENGE. EVERY OPERATION.